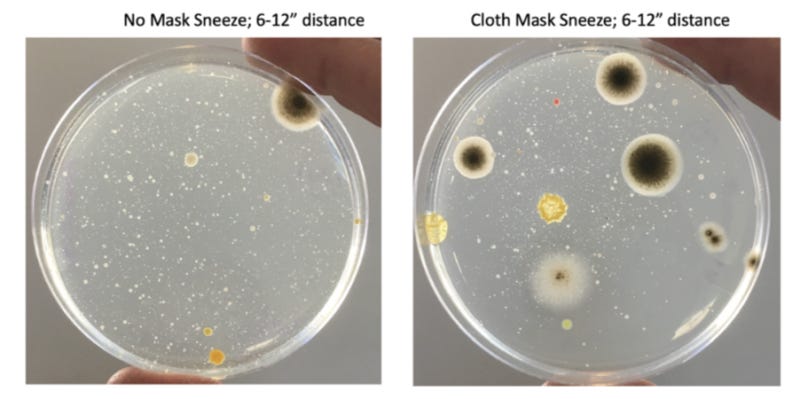
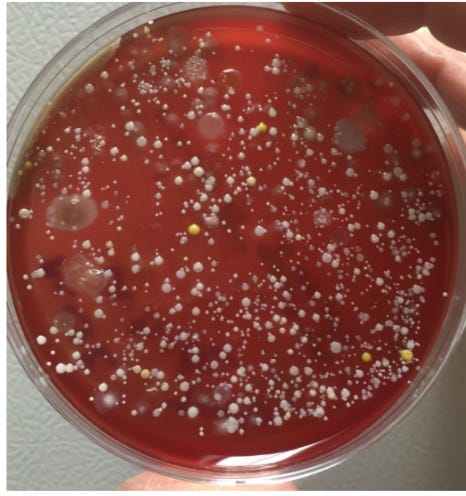

How Lies and Hubris Caused an Awakening
Their lies and hubris caused an awakening. I just hope the people I trust who are now running the major institutions will allocate all resources to programs that will actually improve human health.
BY PAT FIDOPIASTIS
View original article at Brownstone.org.
In March 2020, the phrase “Fifteen days to slow the spread” was transmitting faster than SARS-CoV-2. At the time, it seemed reasonable to want to buy our health care workers a few weeks to prepare. Contemporaneously, Dr. Anthony Fauci reasonably summarized decades of research in his 60 Minutes interview by saying that masks are not an effective way to block respiratory viruses.
In a Snapchat interview, Dr. Fauci reasonably interpreted timely data on Covid-19 outcomes to conclude that young people could decide for themselves if they wanted to meet strangers on a dating app during the pandemic. As Dr. Fauci put it: “Because that’s what’s called relative risk.”
Even the authors of the “proximal origin” opinion piece in Nature Medicine made reasonable points in support of a natural origin of SARS-CoV-2 (despite revealing their cards by calling “lab leak” implausible): “..it is likely that SARS-CoV-2-like viruses with partial or full polybasic cleavage sites will be discovered in other species” and “More scientific data could swing the balance of evidence to favor one hypothesis over another.”
Five years later, thousands of animals have been sampled, millions of genomic sequences have been analyzed, and still there is nothing remotely close to a non-human adapted, animal version of SARS-CoV-2; back in 2003, using “stone tools” compared to today’s technology, they found the animal version of that SARS virus in a few months.
Unfortunately, the honeymoon of reason was brief. Overwhelming evidence that SARS-CoV-2 was not natural became a “destructive conspiracy,” and if you spoke about it, you were somehow racist.
Surgeon General Jerome Adams instructed us on how to make a life-saving mask from an old t-shirt. Dr. Fauci used the bizarre excuse that he lied in his 60 Minutesinterview to explain why he abruptly reversed himself and began promoting the epidemiological theater of wearing several masks at once.
Not to be outdone, Dr. Deborah Birx summed up the futility of her leadership with this pearl: “We know that there are ways that you can even play tennis with marked balls so you’re not touching each other’s balls.” This sounded more like a punchline than worthwhile public health advice. Perhaps most egregious of all, we learned that “Two weeks to slow the spread” was not meant to be taken literally.
For me, a professor of microbiology for nearly 25 years, the moment of reason ended when I stepped into an elevator on my campus and saw a floor sticker telling me where to stand (Fig. 1). I simply could not keep quiet and pretend that this was sound public health advice.
Before long, businesses were inundated with pandemic rules. I was hired by one of the lucky ones deemed “essential,” and therefore allowed to open, to assist with “safe” operation plans.
When I arrived to conduct my inspection, the business looked more like an Ebola field hospital than a furniture store (Fig. 2). Masked customers were herded in the parking lot by ropes and signs. One by one, they were greeted by an attendant, grateful to still have a job, standing behind Plexiglas, wearing a mask and face shield.
The friendly attendant was instructed to ask uncomfortable questions about symptoms like diarrhea. If a customer responded “yes” to any of the symptoms or refused to answer, they could not shop for furniture. If “no,” then their temperature was measured.
It was nearly 100 degrees that day so almost everyone had to be scanned multiple times. Inside the store was a maze of one-way arrows, warning signs, Plexiglas, hand sanitizer stations, and boxes of masks and disposable couch covers. They even had a video monitor reporting the number of customers per 400 square feet of store. Sadly, the epidemiological version of “over-medicating the patient” did not stop with onerous business rules.
Drunk with power, public health officials in California felt ordained to protect the unwashed masses from Thanksgiving dinner. Unsurprisingly, these farcical dining rules did not apply to everyone.
Who actually believed “singing, chanting, shouting, and physical exertion” at a family dinner was too risky? Who decided that we needed to bulldoze a skate park to prevent kids from congregating? Why was it necessary to arrest a lone paddleboarder in Santa Monica Bay for “flouting coronavirus closures?”
In the LA Times article on the paddler’s arrest, a professor from the prestigious Scripps Institute of Oceanography opined, “SARS-CoV-2, the virus that causes COVID-19, could enter coastal waters and transfer back into the air along the coast. I wouldn’t go in the water if you paid me $1 million right now.”
I tried laughing off the ridiculous, unenforceable Thanksgiving rules, those stickers in the elevators, and other nonsense that at the time was happening somewhere else. But I could not get past the frightening reality that so many of my highly educated peers actually believed nonsense like SARS-CoV-2 was leaping out of the ocean.
Anyone paying attention could compile government data on Covid-19 outcomes and assess risk for themselves (Table 1). The message was always the same – the vast majority of deaths attributed to Covid-19 were people over 65 years old with severe comorbidities, especially obesity.
By signing the Great Barrington Declaration and discussing its premise of “focused protection” in my advanced microbiology courses, I received an avalanche of vitriol.
Among the most shocking responses were accusations of “ageism” and “fat-shaming” for discussing hard facts about the pandemic.
Just like that, the “Science doesn’t care about your feelings” crowd started prioritizing their feelings. The university newspaper asked for an interview. I was warned not to accept, but I wanted to start a bigger conversation. I regret my decision because the article they wrote did not represent the views I articulated.
Instead, I was accused of promoting a “power imbalance” by supposedly forcing my “junk science” views on students. I used to think the cries of “fake news” were just a lazy argument by people that could not support their position, until I read that article about me.
Ironically, these same people who attacked me had completely accepted the made-up “six-feet rule,” which was the root of so much collateral damage. Heavily biased news sources like NPR defended this unscientific rule by stating, “distance still protects you.” However, if the cure is not even remotely feasible, despite the best efforts of authoritarians, then it’s not really a cure.
Apparently I crossed the line when I discussed in class how politicized the pandemic had become. How is it that President Trump’s rallies were spreading “coronavirus and death” but BLM protests had no effect on coronavirus cases? The sampling bias was baked in, given that contact tracers were being told not to ask people if they had been to a protest.
Why was it acceptable for CNN to use phrases such as “Wuhan virus” and “Chinese coronavirus,” but when President Trump did it, he was called “racist?” Was it actually “racist” to discuss the obvious signs of genetic manipulation in the SARS-CoV-2 genome with my students in an Emerging Infectious Diseases class?
My campus newspaper and many of my colleagues thought so, as did an Asian American and Pacific Islander group calling for my resignation. When the admonitions about masks became aggressive (Fig. 3), and draconian, unscientific outdoor mask fines were being implemented, I analyzed some data and conducted a few experiments to find out for myself if masks were worth all the anger.
I looked at “cases” in places like New York City and pointed out when the mask mandate and fines were applied (Fig. 4). Notably, the NYC mandate was instituted after cases had already begun to fall, and coercive fines did not prevent the second wave, which was longer and reached a higher peak than the first wave.
I had my allergy-prone daughter sneeze onto petri-plates with and without the CDC-approved masks we wore to enter locations that enforced the mask mandate (Fig. 5). The saliva spray patterns, illustrated by microbial growth on the plates, were virtually indistinguishable.
In the 60 Minutes interview, Dr. Fauci stated that “…often there are unintended consequences…people keep fiddling with the mask and touching their face…”implying that germs collect on masks, making them a source of contagion rather than a barrier.
Indeed, after the sneeze experiment, I stamped the outside of my daughter’s mask onto a petri-plate. The resulting dense microbial growth supported Dr. Fauci’s argument against mask wearing – “fiddling with the mask” probably does spread microbes (Fig. 6).
At the time, I stated in the campus newspaper that “the science on masks was mixed at best.” However, the third-year journalism student apparently knew better and decided I was pushing “junk science.” Was I naïve to expect an apology after “the science” started catching up to what I was saying?
During the pandemic, my lab was responsible for measuring SARS-CoV-2 levels in wastewater (Fig. 7) to use this information as a means of tracking community transmission. We learned two important lessons from this approach.
First, peak levels of SARS-CoV-2 in wastewater (orange line) provided a few weeks’ lead to when we could expect to see peak levels of people testing positive for the virus (i.e., “cases;” blue line). Second, we learned that the mask mandate (red line) did not stop the virus from doing what it wanted. Despite the mask mandate, transmission of SARS-CoV-2 reached unprecedented highs.
Taken together, my findings were supported by decades of research showing that masks are not effective against respiratory viruses, regardless of the quality. Still, the counterargument persisted that wearing an N95 mask suctioned to your face, and constantly replacing it, would have stopped the pandemic.
Again, if the cure is not feasible, then it’s not really a cure, is it? The reality is that there are no convincing data supporting mask mandates, none that even remotely support children being forced to wear saliva-soaked masks, and especially none that would justify people being choked and beaten for opposing them.
The “follow the science” crowd was honing their authoritarian skills in preparation for mandatory vaccinations. The motivation for these mandates was summed up perfectly: “During the Sars crisis in 2003 pharma companies answered the WHO’s call for vaccine research. They invested hundreds of millions of dollars, but then — when the outbreak died away — governments and charities lost interest.” According to epidemiologist Dr. Osterholm “The companies were left holding the bag.”
How could Big Pharma avoid “holding the bag” on a vaccine they hoped would stop a virus that had repeatedly ripped through the world’s population? Not surprisingly, their first order of business was to drop the concept of “natural immunity” into the memory hole, centuries of science be damned. The subtext was if regular people knew that natural immunity was real, they probably would not want the vaccine, especially if they already had Covid-19 a few times.
Leading up to the vaccine rollout, I tested myself regularly using PCR, antibody, and antigen assays. I eventually tested positive and had mild flu-like symptoms. While well-educated friends of mine had gone to such lengths as to move out of their homes to distance themselves from their children and wait for the vaccines, my family chose a different tack. Instead, we huddled, got mild infections (except for my wife, who seemed to be immune), shared some level of natural immunity to the latest version of the virus, and tracked our infections (Table 2).
When I shared the “herd immunity” story with my small social media following, most appreciated hearing something other than doom and gloom. However, others showed a level of vindictiveness that should not have surprised me, given how acceptable it became to wish death on the unvaccinated.
A colleague attempted to shame me in the campus newspaper, while others wondered out loud whether Child Protective Services should be notified. How dare you give your children the sniffles! How dare you use this time of ridiculous “virtual learning” mandates to provide your children with some hands-on experience performing quantitative PCR!
Predictably, my SARS-CoV-2 antibody levels were extremely high after over two weeks of PCR-positivity. While still overflowing with SARS-CoV-2 antibodies, I was scheduled to receive mandatory shots in order to return to campus.
If the world had actually followed the science, my recent PCR positivity and elevated antibody titers should have been a reasonable exemption. Unfortunately, there was no such exemption. Having seen the terrible treatment of my colleague Dr. Kheriaty, I decided we would play the role of guinea pigs and take what would be an all-risk-and-no-reward shot, especially for my kids. That is, there was nothing in it for us except a few days of high fever and injection site swelling, but definite financial reward for everyone in the vaccine supply chain.
As a member of the “laptop class,” the “lockdowns” made my life easier in many ways. While small business owners struggled, I was getting full pay to upload instructional videos to my university students, and occasionally engage with them online. My wastewater epidemiology work was deemed “essential,” so I was permitted to go to my lab to perform those duties for additional compensation.
However, the ad hominem attacks and threats caused me to disengage from further attempts to start a discussion on pandemic policy, which no doubt was their goal. While the world was fighting over toilet paper and shaming each other for “killing grandma,” we tuned out for a while (Fig. 8).
I was surrounded by so much anger that I truly believed I was alone in my heretical views on pandemic policy. However, I officially tuned back in when Dr. Scott Atlas invited me to join a small group called The Academy for Science and Freedom.
Our meeting at the Hillsdale College Kirby Center in Washington, D.C. was the first time I had hope since the pandemic started. We were professors, medical doctors, publishers, and journalists, all united by a common belief that the people in charge abandoned a basic tenet of public health: voluntary instead of coercive measures would protect public trust and induce cooperation.
Despite all the great minds in the room, it was hard to imagine we would ever get to where we are right now. But here we are. Many of the people responsible for lockdowns, forced vaccinations, and covering up the unnatural origin of SARS-CoV-2 are gone.
In their place, are Academy members such as Dr. Tracy Beth Høeg, Dr. Jay Bhattacharya, Dr. Matt Memoli, Dr. Vinay Prasad, Dr. Martin Kulldorff, and Dr. Marty Makary. All of whom were treated far worse than me. The overwhelming rejection of “The Fauci School” of public health policy is vindicating. However, recent headlines suggest there are holdouts refusing to accept that they were fooled: Dr. Høeg is a “vaccine skeptic,” Dr. Memoli “is known for questioning vaccine mandates,” and Dr. Prasad is an “anti-science MAHA extremist.”
The people I trusted probably fooled me on a lot of things I voted for, like the benefits of a 20,000-page health care policy. Who has time to actually read that stuff? However, they were never going to succeed at fooling me about the science of the pandemic.
Their lies and hubris caused an awakening, reminiscent of the scene in The Matrix when Neo emerged from the virtual world to a brutal reality. I just hope the people I trust who are now running the major institutions will allocate all resources to programs that will actually improve human health. In doing so, they should have no problem convincing those holdouts not only that they had been fooled, but who fooled them.